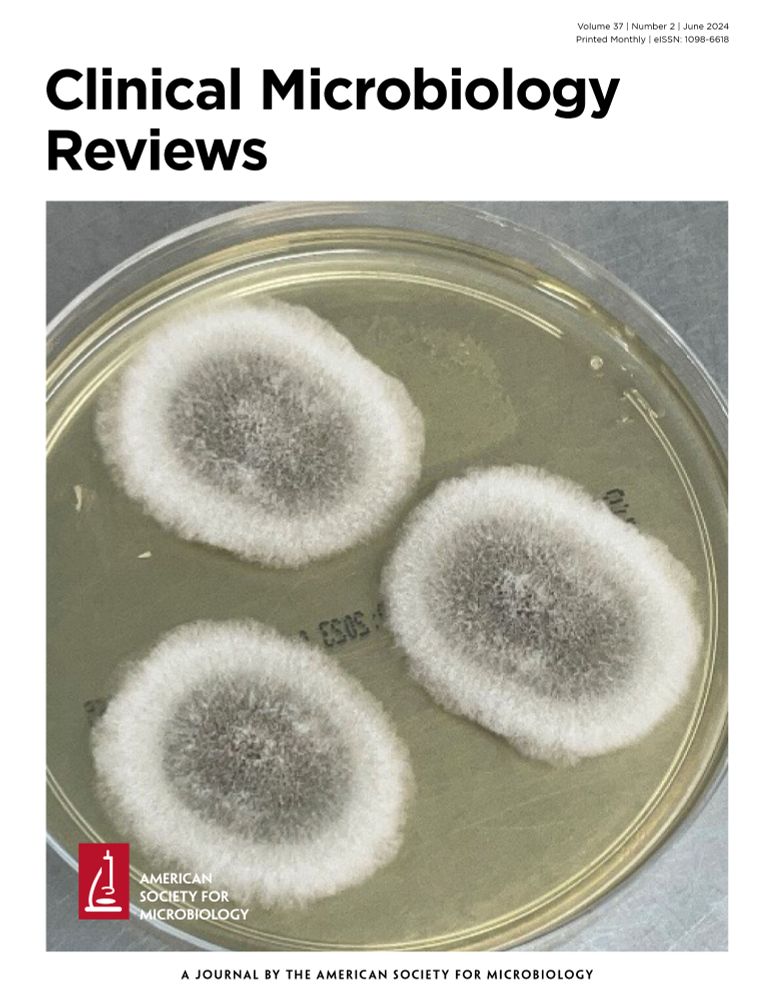

3rd Generation Veteran
Masks and respirators for prevention of respiratory infections: a state of the science review | Clinical Microbiology Reviews journals.asm.org/doi/10.1128/...
Masks and respirators for prevention of respiratory infections: a state of the science review | Clinical Microbiology Reviews journals.asm.org/doi/10.1128/...
citizensadvice.org.uk/policy/publi...
CAB sees it putting 400k people on a "Pathway to Poverty" instead of onto "Pathways to Work"
citizensadvice.org.uk/policy/publi...
CAB sees it putting 400k people on a "Pathway to Poverty" instead of onto "Pathways to Work"
our patient group surveyed your constituents at ASDA, The Jewel, on Friday.
106 surveys completed.
Highlights:
0.00% of people who voted Labour think the benefit cuts are fair.
43.48% of Labour voters in 2024 would vote for Labour in the 2026 election.
our patient group surveyed your constituents at ASDA, The Jewel, on Friday.
106 surveys completed.
Highlights:
0.00% of people who voted Labour think the benefit cuts are fair.
43.48% of Labour voters in 2024 would vote for Labour in the 2026 election.
independentsage.substack.com/p/physician-...

independentsage.substack.com/p/physician-...
anaesthetistsunited.com/legal-update...

It's not mine, it's @brianleishmanmp.bsky.social.
labourlist.org/2025/04/spri...

It's not mine, it's @brianleishmanmp.bsky.social.
labourlist.org/2025/04/spri...
@shubhanna.bsky.social
"a plan to take an ‘unallocated’ £1.5m from a fund that supports unpaid carers to help balance the books. Officials said this was justified"
archive.ph/d7e3A#select...
@shubhanna.bsky.social
"a plan to take an ‘unallocated’ £1.5m from a fund that supports unpaid carers to help balance the books. Officials said this was justified"
archive.ph/d7e3A#select...


We need more proposals like this that co-opt the chaos
Please share off line as well !!!
We need more proposals like this that co-opt the chaos
Please share off line as well !!!
Here’s a list of just some of the lifesaving awards that were terminated. Nearly all were Congressionally mandated. They’ve saved millions of lives. 🧵
Here’s a list of just some of the lifesaving awards that were terminated. Nearly all were Congressionally mandated. They’ve saved millions of lives. 🧵
Donald Trump rejects the explanation
Donald Trump rejects the explanation
– absolutely terrifying where the US is going right now.

– absolutely terrifying where the US is going right now.
Matt Frei, "Like Trump she says she wants closer relations with Vladimir Putin"
"The AfD might be an extremist pariah for many Germans, but in today's Moscow and Washington, she fits right in"
Matt Frei, "Like Trump she says she wants closer relations with Vladimir Putin"
"The AfD might be an extremist pariah for many Germans, but in today's Moscow and Washington, she fits right in"
- how can we all help out?

- how can we all help out?



